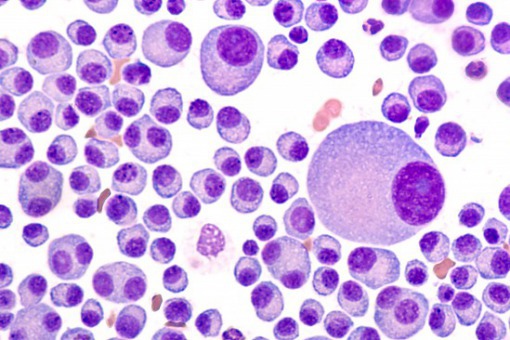

Czy COVID-19 przyśpieszy ewolucję w leczeniu szpiczaka plazmocytowego?
Chorzy na szpiczaka plazmocytowego, których układ odpornościowy jest osłabiony, są bardziej podatni na zakażenie koronawirusem i są pacjentami podwyższonego ryzyka cięższym przebiegiem Covid-19. Pandemia wymusza zmiany w prowadzeniu takich pacjentów. Jakie zmiany są najważniejsze?
Najważniejsze bezpieczeństwo pacjentów
Już w kwietniu/maju 2020 r, w klinikach hematologicznych zauważono „skracanie się” kolejek, pacjenci trafiali rzadziej i zdecydowanie później niż powinni. Początkowa faza pandemii tak wystraszyła pacjentów, że część z nich ignorowała wyniki badań i objawy choroby. W związku z tym zostało wprowadzone szereg rekomendacji i zaleceń, aby można było utrzymać diagnostykę i leczenie pacjentów hematoonkologicznych z bezpieczeństwem dla nich, jednocześnie minimalizując ekspozycje pacjentów na ryzyko zakażenia wirusem Sars-COV-2
Wśród rozwiązań stosowanych przez oddziały leczące nowotwory krwi było zaopatrzenie pacjentów, przeciw zdarzeniom kostnym na które chorzy na szpiczaka są narażeni, układanie grafików przyjęć pacjentów na czas podanie leku, aby minimalizować styczność między sobą i skracanie czasu pobytu w placówce.
Bezpieczeństwo leczenia, możliwe do poprawy
Aktualnie toczy się wiele badań nad wprowadzeniem nowych terapii dla pacjentów chorych na szpiczaka. Są to terapie na różnych etapach rozwoju, część z nich we wczesnych fazach badań, część już zarejestrowana. Środowiska zarówno pacjentów jak i lekarzy oczekuje, że dostępność do tych terapii w Polsce będzie rosnąć i tak się dzieje. Część trafia do refundacji jak np. dwa nowe schematy leczenia odpowiednio karfilzomib+deksametazon oraz schemat trójlekowy iksazomib+lenalidomid+deksametazon, które będą dostępne dla pacjentów od 1 maja.
- W ostatnich latach dostęp do nowoczesnych terapii w Polsce poprawił się, co może wpłynąć na poprawę przeżycia chorych ze szpiczakiem plazmocytowym - stwierdził prof. dr. hab. Krzysztof Giannopoulos z Zakładu Hematoonkologii Doświadczalnej Uniwersytetu Medycznego w Lublinie – jednak są terapie, które w dobie pandemii powinny również być dostępne.
Przy zarządzeniach i rekomendacjach m.in. MZ, które zwracają szczególną sprawę na bezpieczeństwo pacjentów, to leczenie podskórne daratumumabem - myślę, że ta opcja leczenia wpisuje się w politykę MZ w sprawie zmniejszania ekspozycji pacjentów na ryzyko zakażeniem Covid-19, podanie to skraca pobyt pacjenta w szpitalu, można zarządzać obecnością pacjentów w klinice – powiedział prof. Giannopoulos - Nie narażamy pacjenta również na zakładanie portu do podania dożylnego, a różnica w pobycie pacjenta w podaniu podskórnym vs dożylnego to kilka godzin.
Profesor Giannopoulos dodał również, że podanie podskórne stosuje się juz w większości krajów europejskich, jako zamiennik podania dożylnego gdyż jest tożsamy farmakologicznie a daje wiele przewag, m.in. w prowadzeniu pacjentów jako 50% poprawa działań niepożądanych związanych z miejscem podania leku.
Ekonomika leczenia
Nowa forma podania może również optymalizować część kosztową terapii ponieważ nie trzeba dostosowywać dawki, ze względu na wagę pacjenta. Należy podkreślić, że na dziś terapia leczenia szpiczaka plazmocytowego, przy podaniu dożylnym to od 400 minut przy podaniu pierwszej dawki, a kolejnych ok. 200 minut. Przy podaniu podskórnym czas skraca się do jedynie 5 minut! Co pozwala na krótki pobyt w szpitalu, łatwiejsze zarządzanie rotacją pacjentów i obsadą personelu medycznego. Przy stałych niedoborach kadr medycznych jest to bardzo istotne.
Już w kwietniu/maju 2020 r, w klinikach hematologicznych zauważono „skracanie się” kolejek, pacjenci trafiali rzadziej i zdecydowanie później niż powinni. Początkowa faza pandemii tak wystraszyła pacjentów, że część z nich ignorowała wyniki badań i objawy choroby. W związku z tym zostało wprowadzone szereg rekomendacji i zaleceń, aby można było utrzymać diagnostykę i leczenie pacjentów hematoonkologicznych z bezpieczeństwem dla nich, jednocześnie minimalizując ekspozycje pacjentów na ryzyko zakażenia wirusem Sars-COV-2
Wśród rozwiązań stosowanych przez oddziały leczące nowotwory krwi było zaopatrzenie pacjentów, przeciw zdarzeniom kostnym na które chorzy na szpiczaka są narażeni, układanie grafików przyjęć pacjentów na czas podanie leku, aby minimalizować styczność między sobą i skracanie czasu pobytu w placówce.
Bezpieczeństwo leczenia, możliwe do poprawy
Aktualnie toczy się wiele badań nad wprowadzeniem nowych terapii dla pacjentów chorych na szpiczaka. Są to terapie na różnych etapach rozwoju, część z nich we wczesnych fazach badań, część już zarejestrowana. Środowiska zarówno pacjentów jak i lekarzy oczekuje, że dostępność do tych terapii w Polsce będzie rosnąć i tak się dzieje. Część trafia do refundacji jak np. dwa nowe schematy leczenia odpowiednio karfilzomib+deksametazon oraz schemat trójlekowy iksazomib+lenalidomid+deksametazon, które będą dostępne dla pacjentów od 1 maja.
- W ostatnich latach dostęp do nowoczesnych terapii w Polsce poprawił się, co może wpłynąć na poprawę przeżycia chorych ze szpiczakiem plazmocytowym - stwierdził prof. dr. hab. Krzysztof Giannopoulos z Zakładu Hematoonkologii Doświadczalnej Uniwersytetu Medycznego w Lublinie – jednak są terapie, które w dobie pandemii powinny również być dostępne.
Przy zarządzeniach i rekomendacjach m.in. MZ, które zwracają szczególną sprawę na bezpieczeństwo pacjentów, to leczenie podskórne daratumumabem - myślę, że ta opcja leczenia wpisuje się w politykę MZ w sprawie zmniejszania ekspozycji pacjentów na ryzyko zakażeniem Covid-19, podanie to skraca pobyt pacjenta w szpitalu, można zarządzać obecnością pacjentów w klinice – powiedział prof. Giannopoulos - Nie narażamy pacjenta również na zakładanie portu do podania dożylnego, a różnica w pobycie pacjenta w podaniu podskórnym vs dożylnego to kilka godzin.
Profesor Giannopoulos dodał również, że podanie podskórne stosuje się juz w większości krajów europejskich, jako zamiennik podania dożylnego gdyż jest tożsamy farmakologicznie a daje wiele przewag, m.in. w prowadzeniu pacjentów jako 50% poprawa działań niepożądanych związanych z miejscem podania leku.
Ekonomika leczenia
Nowa forma podania może również optymalizować część kosztową terapii ponieważ nie trzeba dostosowywać dawki, ze względu na wagę pacjenta. Należy podkreślić, że na dziś terapia leczenia szpiczaka plazmocytowego, przy podaniu dożylnym to od 400 minut przy podaniu pierwszej dawki, a kolejnych ok. 200 minut. Przy podaniu podskórnym czas skraca się do jedynie 5 minut! Co pozwala na krótki pobyt w szpitalu, łatwiejsze zarządzanie rotacją pacjentów i obsadą personelu medycznego. Przy stałych niedoborach kadr medycznych jest to bardzo istotne.



